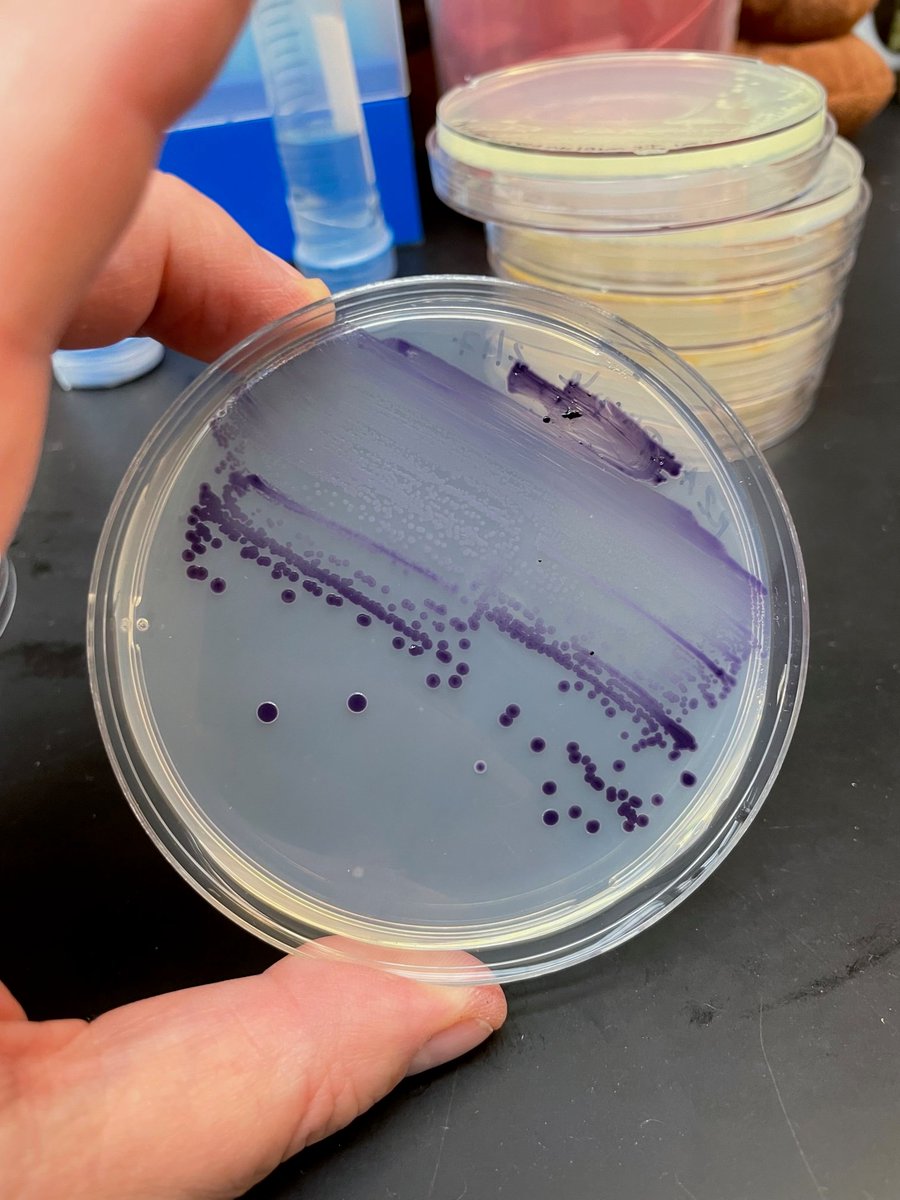
Mark O. Martin tweet media

Jude Lab
272 posts

Jude Lab
@JudeLab_Bard
Associate professor - Researching aquatic microbes in the Hudson River Valley; interested in teaching #scicomm and mentoring; Bard House Professor Yauch ‘86


Had my last class with my first Dartmouth undergrads yesterday. They are such incredible humans. Now reading their reflections and truly amazed with how effective the Calderwood Seminars in Public Writing model has been in my first-year writing class! calderwoodseminars.org +


#WomanWednesday: Microbiologist and Associate Professor of Biology at @BardCollege, @violetmicrobe will lead a project to regenerate natural fabric dyeing processes with traditional Moroccan weavers as part of a #Daughters4Earth grant awarded to @Atw80Fabrics. 🔬

Consider joining us in the Biology Program @BardCollege ! We’re hiring 2 tenure track open rank faculty- details here: bard.edu/humanresources…

Introducing the Microbes and Social Equity Working Group: Considering the Microbial Components of Social, Environmental, and Health Justice sueishaqlab.org/2021/07/27/int…



Entries are closed, but you can participate by voting for your favorite. Here's the link to the People's Choice. Winner of this category gets a pretty rad trophy. pollunit.com/en/polls/bbhmo…

Entries are closed, but you can participate by voting for your favorite. Here's the link to the People's Choice. Winner of this category gets a pretty rad trophy. pollunit.com/en/polls/bbhmo…




